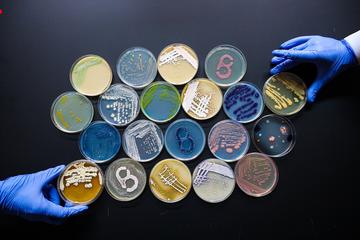
Petri dishes colourfully displayed

MARK WILKINSON

MARK WILKINSON
Oxford alumni are fighting antimicrobial resistance (AMR) in novel ways
Published: 11 March 2026
Author: Richard Lofthouse
Share this article
Bactobio was hatched in May 2020, a baby of the pandemic. Mark Wilkinson (LMH, 2010; shown right) is co-founder with Dan Hansen (Harris Manchester, 2008), and remembers how strange it was. ‘The rest of the world had stopped but we were going at full tilt, exactly as you’d think a start-up would be.’
Six years later, the company is thriving after multiple seed-funding rounds amounting to approximately £18 million, plus valuable grants from Innovate UK.
Occupying mixed office and laboratory space in Vauxhall, London, the company boasts about 40 employees, of whom over 30 are scientists with PhDs.
The ‘problem’ the company is trying to solve splits into two camps.
The first is antimicrobial resistance (AMR) affecting healthcare. ‘People may have heard of antibiotics becoming less effective owing to overuse and misuse. This is true – but the problem, if anything, is more urgent than people generally understand. Routine surgery requires antibiotic treatment to prevent infection, plus many lesser conditions such as urinary tract infections. If the antibiotics were to fail completely, modern medicine would fail with it.’
‘The second big area where we work is fungicides in an agricultural setting where, for example, we have a small plot trial beginning in March in Norfolk, where we have novel chemicals that will be applied to wheat to prevent wheat blotch.’
Threats to medicine and food security represent systemic, even existential threats to human wellbeing and survival in the twenty-first century, a fact that is not sufficiently understood.
Mark says that when the company began in 2020, 700,000 people a year globally were dying as a result of AMR. ‘Six years later it has risen to 1.3 million – almost doubling – and that figure may be 5 million by 2030.’
The solution may lie in interrogating at a much faster, wider rate than was historically possible thousands of bacteria that in certain combinations can amount to a novel chemical.
Mark explains that a single gram of soil will have as many as 10,000 different living bacterial species in it. Brought into a lab, perhaps 100 will survive. Using machine learning from proprietary software, the company is isolating and cultivating new chemicals by isolating these bacteria. So far it has already discovered more than ten new antimicrobial chemicals never seen before, a process that would normally take many years, he says.
‘We are conducting 50,000 experiments a year and have already identified 5,000 bacteria, of which 2,500 have never been cultured before, amounting to over 10% of the global bank of approximately 21,000 bacteria that have been cultured previously, spanning all academic and commercial sources.’
The specialist knowledge within the workforce spans software engineers, data scientists and bioinformaticians. Mark is keen to point out that the method deployed here unlocks a natural process, speeding it up with software and computing power.
The bigger game plan involves a larger Series A fundraise later this year, and commercialisation of the pathogen-hunting compounds via licensing. ‘I would like us to be a billion-dollar company; we are building a biotechnology company to scale.’
Mark says that the company hires external legal support, has its own product team, and excellent in-house expertise via a board and investors that include Hugh Grant, the former head of agritech giant Monsanto.
Mark went to Lady Margaret Hall where he studied biochemistry. He spent the fourth year researching the parasite that causes malaria. He then attended Imperial College London for his PhD. He worked at pharma giant GSK but a plan to move to New York was thwarted by lockdown, inadvertently making the space in which the two founders made their big leap.
Living now in Camberwell, where the first soil samples came from a tiny garden plot, Mark says that some of the best soil came from a sampling from Epping Forest where the absence of chemicals means that the bacteria are ‘fighting fit and all competing with each other, which is what we want’. Equally, they take samples from existing farmland, the objective being to get a diversity.
His Oxford links remain incredibly strong, so much so that he is currently supervising an Oxford DPhil student alongside Oxford Professor Craig MacLean, via an Oxford Interdisciplinary Bioscience CASE studentship.
‘There’s still the academic in me…it’s a collaborative atmosphere these days between academia and industry.’
Mark also notes that already in 2026 he met up with several LMH friends and they went wild swimming in the swollen River Thames in Port Meadow [Truly brave! Ed].
Since graduation in 2014, Mark notes that the biochemistry department at Oxford, tucked behind the Pitt Rivers Museum, has physically doubled in size, a remarkable fact.
Alexander Fleming, who discovered penicillin in 1928, was at the time at Imperial College London, whilst it was Florey, Chain and colleagues at Oxford’s Dunn School of Pathology who later developed it into a life-saving medicine.
‘This historic linkage between Imperial and Oxford seems to continue, with Dan and I also attending both institutions – it’s a nice coincidence.’
Ineos Oxford Institute for antimicrobial research (IOI) is a world-leading centre of research, training and education based at the University of Oxford. It was established thanks to an unprecedented £100 million gift from INEOS, one of the world’s largest chemical companies.
It seems like an obvious vector for competition between private and ‘public’ sectors, but Mark disputes the distinction, saying that the ultimate goals are shared, and that ‘the atmosphere is very collaborative’ across disciplines, funding streams, knowledge discovery and even geographies.
Just back from a San Francisco JP Morgan Healthcare summit, Mark’s only cautionary comment is that while many, if not most US graduates seem to want to be part of risky but exciting start-ups, many British graduates, as he sees it, still want safe berth in other corporate and institutional settings. He would like a more vibrant risk appetite among both funders and entrepreneurs, including Oxford graduates.
Dr Mark Wilkinson is the Chief Scientific Officer at Bactobio. After studying Biochemistry in Oxford, he obtained a PhD in Infectious Disease from Imperial. Mark was previously an Innovation Fellow at GSK.
Dr Daniel Hansen is the Chief Executive Officer at Bactobio. After studying Human Sciences in Oxford, he obtained a PhD in Microbiology from Imperial. Dan was previously an investment banker at Barclays.
Photography by Acacia Diana/Bactobio. Dan is on the left and Mark is on the right, in the lead image.,















